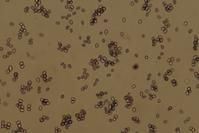
白乳菇孢子，100倍，澱粉質反應

信息
中文名:梅爾澤試劑 梅爾澤試劑
梅爾澤試劑外文名:Melzer'sreagent
成分:水,氯醛,碘,碘化鉀
用途:輔助鑑定真菌
毒性:有毒
注意事項:不能與鹼混用
化學成分
梅爾澤試劑是氯醛,碘化鉀和碘的水溶液。根據不同的配方,它含2.50-3.75%碘化鉀和0.75-1.25%碘, 白肉色鵝膏菌孢子,1.2倍,非澱粉質反應
白肉色鵝膏菌孢子,1.2倍,非澱粉質反應顏色反應
 Amanita flavorubescens,1.2倍,澱粉質反應
Amanita flavorubescens,1.2倍,澱粉質反應使用梅爾澤試劑時只需使試劑接觸到真菌組織或細胞(通常是準備好的顯微鏡載玻片),然後觀察是否出現以下三種顏色反應:
●澱粉質(amyloid)或梅爾澤陽性反應:被測組織顏色呈藍色到黑色。
●擬澱粉質(pseudoamyloid)或似糊精反應(dextrinoid):被測組織呈棕色到紅棕色。
●非澱粉質或梅爾澤陰性反應:被測組織不改變顏色,或顯淺黃棕色。在澱粉質反應中,還可以區分兩種類型:
澱粉質反應
●真澱粉質(euamyloid)反應:被測組織可在未經氫氧化鉀預處理的情況下變藍。
白乳菇孢子,100倍,澱粉質反應
白乳菇孢子,100倍,澱粉質反應●半澱粉質(hemiamyloid)反應:被測組織在魯戈爾溶液中變紅,但在梅爾澤試劑中沒任何反應;用氫氧化鉀預處理後在兩種試劑中均變藍。
梅爾澤試劑的反應幾乎是立即發生的,不過在某些情況下需要20分鐘才能看到反應現象。
構成梅爾澤試劑的化合物有多重功能。氯醛是一種清潔劑,用於漂白和提高很多種暗顏色物質的透明度。碘化鉀是用來提高碘的溶解度,無碘化鉀時碘在水中只是半可溶。碘被認為是梅爾澤試劑中主要的染色劑,它與澱粉質物質細胞壁中類似澱粉的多糖發生反應。然而,具體的反應機理還不清楚。
 高大環柄菇,100倍,擬澱粉質反應
高大環柄菇,100倍,擬澱粉質反應高大環柄菇,100倍,擬澱粉質反應在一項包括35種擔子菌孢子的測試中,大部分孢子在梅爾澤試劑和魯戈爾試劑中產生不同的反應結果。有些孢子在梅爾澤試劑中無反應,但在魯戈爾試劑中,結果從微弱或無反應,到碘陽性反應;有些孢子在梅爾澤試劑中給出澱粉質反應而在魯戈爾試劑中甚至給出擬澱粉質反應。當與鹼性溶液混合時,梅爾澤試劑退化為渾濁的沉澱,因此它不能跟像氫氧化鉀或氨水這樣的常用真菌學試劑混合使用或直接相繼使用。當用氫氧化鉀做預處理時,必須在加梅爾澤試劑前中和鹼性。
歷史
使用碘溶液來輔助描述和鑑定真菌的歷史可以追溯到19世紀中期。梅爾澤試劑在1924年首次由真菌學家瓦茨拉夫·梅爾澤發明並作出描述,並以它的發明者的名字命名。梅爾澤修改了植物學家阿瑟邁耶多年前開發的一種含氯醛的IKI溶液而得到了梅爾澤試劑。梅爾澤是紅菇屬(Russula)的專家,在該屬中,孢子紋飾或整個孢子的澱粉質分析具有十分重要的意義。

